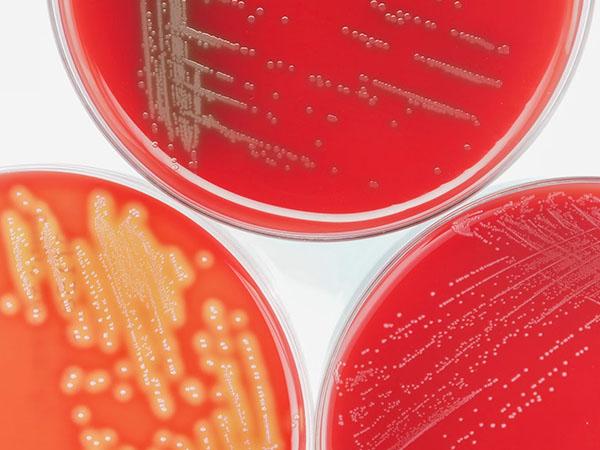
MERCK, Darmstadt

Worauf kommt es beim Design Ihres Führungskräfte-Entwicklungsprogramms an? Was sollten Sie in jedem Fall berücksichtigen und welche typischen Fehler vermeiden?
Sara Kaufmann und Katharina Faith geben entlang von Beispielen praxisorientierte Einblicke in die Do's und Don'ts des Aufbaus und Designs von Leadership Development Programmen. Unser Gastreferent Metin Aydin, Head of Skillmanagement Deutsche Telekom, liefert zudem zu einem der vorgestellten Kriterien spannende Einblicke in die von der Deutsche Telekom entwickelten Lösung.
Nach dem einstündigen Termin wissen Sie:
> an welchen unternehmerischen Dimensionen Sie Ihr Konzept aufhängen sollten,
> welche Strategien erfolgreiche Programme aufweisen,
> wie Sie die Leistungsfähigkeit des Programms messen können.
Ihr Führungskräfteprogramm soll die Weichen für den Erfolgskurs Ihres Unternehmens stellen - wir möchten Sie unterstützen, alle Entscheidungen dazu pragmatisch & informiert zu treffen!
Was:
Webinar "Best Practices zum Design von Leadership Development Programmen"